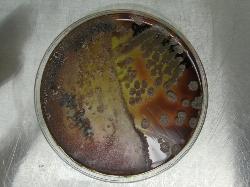

| Bacillus licheniformis |
| Bacillus licheniformis cells & spores; Gram-staining |
| B. licheniformis colonies on Sheep blood agar |
Taxonomy
Morphology
Cultural characteristics
Biochemical characters
Ecology
Pathogenicity
References
Phylum Bacillota (Firmicutes), Class Bacilli, Order Caryophanales, Family Bacillaceae, Genus Bacillus, Bacillus licheniformis
(Weigmann 1898) Chester 1901.
Old synonyms: Clostridium licheniforme Weigmann 1898, Denitrobacillus licheniformis (Weigmann) Verhoeven 1952.
Probable synonyms: Semiclostridium commune Maassen 1907,
Bacillus tinakiensis Kurochkin 1958.
(Weigmann 1898) Chester 1901.
Old synonyms: Clostridium licheniforme Weigmann 1898, Denitrobacillus licheniformis (Weigmann) Verhoeven 1952.
Probable synonyms: Semiclostridium commune Maassen 1907,
Bacillus tinakiensis Kurochkin 1958.
Gram-positive, straight or slightly curved rods, 1.5-3.0 x 0.6-0.8 μm in diameter,
motile by peritrichous flagella. Ellipsoidal or cylindrical, central, paracentral or
subterminal spore, not deforming the vegetative cell. No capsule present.
motile by peritrichous flagella. Ellipsoidal or cylindrical, central, paracentral or
subterminal spore, not deforming the vegetative cell. No capsule present.
Aerobic, facultatively anaerobic. Growth temperature from 15 ºC to 50-55 ºC. Colonial
morphology is variable, and may give the appearance of a mixed culture. Colonies are
round to irregular in shape, 2-4 mm in diameter, with margins varying from undulate
to fimbriate. Color is whitish and may become brown.
On agar media: colonies become opaque with dull to rough surface, hair-like
outgrowts ("licheniform"), attached strongly to agar. Red pigment formed by many
strains on carbohidrate media containing iron. Aged cultures may become brown.
Usually nonhemolytic on blood agar.
Growth active at pH 5.7-6.8. Growth in 2-7% NaCl (12% for strains isolated from
human faeces). NaCl, allantoin or urate are not required for growth.
morphology is variable, and may give the appearance of a mixed culture. Colonies are
round to irregular in shape, 2-4 mm in diameter, with margins varying from undulate
to fimbriate. Color is whitish and may become brown.
On agar media: colonies become opaque with dull to rough surface, hair-like
outgrowts ("licheniform"), attached strongly to agar. Red pigment formed by many
strains on carbohidrate media containing iron. Aged cultures may become brown.
Usually nonhemolytic on blood agar.
Growth active at pH 5.7-6.8. Growth in 2-7% NaCl (12% for strains isolated from
human faeces). NaCl, allantoin or urate are not required for growth.
Spores occur in soil, on bird feathers and in ground dwelling birds and aquatic species;
may survive severe heat treatment. Vegetative growth in many foods, especially if held
at 30-50 ºC. An isolate from a geothermal environment with a maximum growth
temperature of 68 ºC has been reported. Growth in the presence of lysozyme is variable.
Penicillinase inducible. Polypeptide antibiotics are produced (bacitracin).
may survive severe heat treatment. Vegetative growth in many foods, especially if held
at 30-50 ºC. An isolate from a geothermal environment with a maximum growth
temperature of 68 ºC has been reported. Growth in the presence of lysozyme is variable.
Penicillinase inducible. Polypeptide antibiotics are produced (bacitracin).
B. licheniformis, B. subtilis and B. pumilus comprise the subtilis group, which has been associated with food-borne gastro-enteritis.
B. licheniformis has also been associated with septicaemia, peritonitis, ophthalmitis and food poisoning in humans, as well as with
bovine toxaemia and abortions. Strains isolated from human faeces are hemolytic. A strain isolated from cow milk was also hemolytic
- admin note. Occasionally reported as an opportunistic pathogen in man and other animals. Adhere to Hep-2 cells (strains isolated
from human faeces) with damage effect (moderate vacuolisation).
B. licheniformis has also been associated with septicaemia, peritonitis, ophthalmitis and food poisoning in humans, as well as with
bovine toxaemia and abortions. Strains isolated from human faeces are hemolytic. A strain isolated from cow milk was also hemolytic
- admin note. Occasionally reported as an opportunistic pathogen in man and other animals. Adhere to Hep-2 cells (strains isolated
from human faeces) with damage effect (moderate vacuolisation).
- Bîlbîie V., Pozsgi N., 1985, Bacteriologie Medicala, vol.ll, Ed. Medicala, Bucuresti.
- Gordon R.E., Haynes W.C., Pang C.H. (1973) – The genus Bacillus . Agriculture Handbook No. 427, U.S.D.A., Washington D.C.
- Buchanan R.E., Gibbons N.E., Cowan S.T., Holt J.G., Liston J., Murray R.G.E., Niven C.F., Ravin A.W., Stanier R.W. ( 1974) –
Bergey’s Manual of Determinative Bacteriology, Eight Edition, The Williams & Wilkins Company, Baltimore. - Buiuc D., Negut M. , 1999. Tratat de Microbiologie Clinica, Editura Medicala, Bucuresti.
- N.A. Logan and P. De Vos, 2009. Genus I. Bacillus Cohn 1872. In: (Eds.) P.D. Vos, G. Garrity, D. Jones, N.R. Krieg, W. Ludwig, F.A.
Rainey, K.-H. Schleifer, W.B. Whitman. Bergey’s Manual of Systematic Bacteriology, Volume 3: The Firmicutes, Springer, 21-127. - Hoyles L., Honda H., Logan N.A., Halket G., La Ragione R., McCartney A.L., 2012. Recognition of greater diversity of Bacillus
species and related bacteria in human faeces. Research in Microbiology 163, 3-13. - Liu B, Liu GH, Cetin S, Schumann P, Pan ZZ, Chen QQ. Bacillus gobiensis sp. nov., isolated from a soil sample. Int J Syst Evol
Microbiol 2016; 66:379-384.
Positive results for arginine dihydrolase, hydrolysis of esculin, beta-galactosidase,
egg yolk reaction, nitrate reduction, phenylalanine deamination, Voges-Proskauer
test, acid production from: N-acetyl-D-glucosamine, amygdalin, L-arabinose, arbutin,
D-cellobiose (type strain is negative in Liu's study), D-fructose, galactose,
beta-gentibiose, glycerol, glycogen, lactose, D-mannose, maltose, ribose, salicin,
starch, sorbitol, sucrose, tagatose, turanose and trehalose.
Negative results for H2S production, hippurate hydrolysis, indole production, lysine
decarboxylase, ornithine decarboxylase, tryptophan deaminase, tyrosine degradation,
acid production from: D- and L-fucose, methyl beta-xyloside, D-arabinose, D- and
L-arabitol, adonitol, dulcitol, erythritol, gentibiose, gluconate, 2- or 5-ketogluconate,
lyxose, D-melezitose, sorbose, xylitol and L-xylose.
Variable results for oxidase, urease, acid production from: meso-inositol, inulin,
D-melibiose, D-raffinose and rhamnose.
egg yolk reaction, nitrate reduction, phenylalanine deamination, Voges-Proskauer
test, acid production from: N-acetyl-D-glucosamine, amygdalin, L-arabinose, arbutin,
D-cellobiose (type strain is negative in Liu's study), D-fructose, galactose,
beta-gentibiose, glycerol, glycogen, lactose, D-mannose, maltose, ribose, salicin,
starch, sorbitol, sucrose, tagatose, turanose and trehalose.
Negative results for H2S production, hippurate hydrolysis, indole production, lysine
decarboxylase, ornithine decarboxylase, tryptophan deaminase, tyrosine degradation,
acid production from: D- and L-fucose, methyl beta-xyloside, D-arabinose, D- and
L-arabitol, adonitol, dulcitol, erythritol, gentibiose, gluconate, 2- or 5-ketogluconate,
lyxose, D-melezitose, sorbose, xylitol and L-xylose.
Variable results for oxidase, urease, acid production from: meso-inositol, inulin,
D-melibiose, D-raffinose and rhamnose.

(c) Costin Stoica

| Antibiogram |
| Encyclopedia |
| Culture media |
| Biochemical tests |
| Stainings |
| Images |
| Movies |
| Articles |
| Identification |
| Software |
| R E G N U M PROKARYOTAE |

| Back |